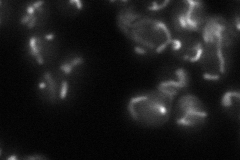
YOR271C
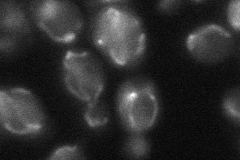
YOR271C

View description
Putative protein, predicted to be an alpha-isopropylmalate carrier; belongs to the sideroblastic-associated protein family; non-tagged protein is detected in purified mitochondria; likely to play a role in iron homeostasis
Localization:
Intensity:
Fold change:
Significance:
-
C’ GFP library in SD

below threshold15.34 -
N' NOP1pr-GFP in SD

mitochondria172.93 -
N' TEF2pr-mCherry in SD

mitochondria165.196 -
N' NATIVEpr-GFP in SD
mitochondria51.2111 -
N' TEF2pr-VC and Cyto-VN in SD
mitochondria34.051 -
C’ GFP library in SD+DTT

cytosol14.320.93No -
C’ GFP library in SD+H2O2

cytosol13.710.89No -
C’ GFP library in Starvation Media

cytosol171.1No -
C’ GFP library on the background of Pup2-DaMP

below threshold -
C’ GFP library on the background of CCT mutant

below threshold14.62430.953114No
